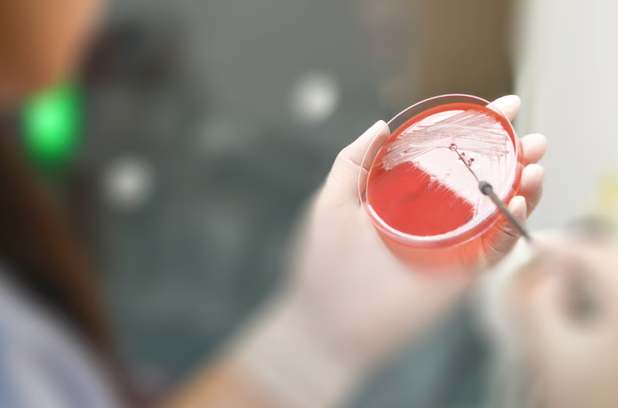

Nga Gazeta Si- Ngjashëm me pragun e njohur të klimës prej 1.5 gradë Celsius, rëndësia e kufijve kritikë në mjedisin tonë është kuptuar prej kohësh si çelësi për të na ndihmuar të shmangim fatkeqësitë. Thënë kjo, kur e dimë se bota po përballet me një krizë në rritje të rezistencës antimikrobike (AMR), por nuk është përcaktuar një pikë kthese përfundimtare, kjo na lë në një rrugë potencialisht të rrezikshme.
Këtë javë, Organizata Botërore e Shëndetësisë (OBSH) publikoi një raport që sugjeron se tani mund të kemi arritur një prag kaq kritik.
Duke u bazuar në të dhëna nga më shumë se 100 vende, raporti zbuloi se infeksionet rezistente ndaj ilaçeve janë rritur ndjeshëm vitet e fundit, duke përfaqësuar një të tretën e të gjitha infeksioneve në disa rajone.
Këto gjetje i shtohen një numri gjithnjë e në rritje provash që sugjerojnë se infeksionet më të vështira për t’u trajtuar po fillojnë të tejkalojnë zhvillimin e antibiotikëve, ose sepse antibiotikët e duhur nuk po i arrijnë njerëzit që kanë nevojë për to, ose sepse ato nuk po zhvillohen fare. Si rezultat, numri i vdekjeve nga AMR pritet të rritet ndjeshëm, me 70% deri në vitin 2050.
Duke pasur parasysh sasinë e fokusit dhe financimit që po shkon në inkurajimin e kompanive farmaceutike për të investuar në kërkim dhe zhvillim, mesazhi që duhet të marrim nga kjo është se nuk mjafton vetëm të zhvillohen antibiotikë të rinj.
Ato duhet të jenë antibiotikët e duhur, ato që synojnë infeksionet që kanë ndikimin më të madh në shëndetin publik. Ky nuk është rasti. Ka rreth 90 antimikrobikë në zhvillim klinik, dhe nga ato inovative, jo variante të antibiotikëve ekzistues, vetëm pesë synojnë të paktën një nga “patogjenët prioritarë” të OBSH-së, infeksionet rezistente ndaj shumë ilaçeve që përbëjnë kërcënimin më të madh për njerëzit. Me fjalë të tjera, ne nuk po i zëvendësojmë antibiotikët që po humbasin për shkak të rezistencës dhe, siç tregon raporti i OBSH-së, pasojat më në fund po fillojnë të ndihen.
Situata nuk ndihmohet nga një mungesë e madhe e të dhënave. Pavarësisht progresit të madh në përmirësimin e mbikëqyrjes së AMR-së në të gjithë globin, boshllëqet në të dhënat tona vazhdojnë, veçanërisht në shumë vende me të ardhura të ulëta dhe të mesme ku barra e sëmundjeve është më e madhe.
Ajo që dimë është se njerëzit nuk po marrin antibiotikët që u nevojiten. Një hulumtim i kryer këtë vit zbuloi se nga më shumë se 1.5 milion raste të atyre që njihen si infeksione Gram-negative – infeksione serioze dhe të vështira për t’u trajtuar, në tetë vende më të varfra, antibiotikët e duhur ishin të disponueshëm mesatarisht në vetëm 6.9% të rasteve. Në disa vende, ishte vetëm 0.2%.
Nevojitet një ndryshim rrënjësor, jo vetëm në përgjigjen ndaj AMR-së, por edhe në adresim. Deri më tani, kjo e fundit është përqendruar me të drejtë në përdorimin e tepërt të antibiotikëve. Kjo nuk është më e mjaftueshme. Për të shmangur pikën kthese, ne gjithashtu duhet të adresojmë mungesën e aksesit që po nxit gjithashtu AMR-në. Sepse nëse antibiotikët e duhur nuk zhvillohen ose nuk vihen në dispozicion dhe nëse infeksionet lihen të mos trajtohen, kjo u jep baktereve mundësinë të përhapen dhe të zhvillojnë rezistencë, duke i bërë infeksionet më të vështira për t’u trajtuar në planin afatgjatë. Mënyra për ta shmangur këtë është të përqendrohen përpjekjet në përshpejtimin e inovacionit të antibiotikëve dhe në përpjekjet për të rritur përdorimin e tyre të duhur.
Do të jetë e rëndësishme që bota të njohë dhe të pranojë se kemi arritur në këtë pikë kthese. Pothuajse saktësisht një vit më parë, kur deklarata politike e AMR u miratua në asamblenë e përgjithshme të OKB-së, u ra dakord edhe për objektiva të reja. Këto përfshinin forcimin e sistemeve globale shëndetësore, ndjekjen e një qasjeje “Një Shëndet” për të koordinuar përpjekjet në të gjithë sektorët e shëndetit të njeriut, shëndetit të kafshëve dhe mjedisit, dhe objektiva për forcimin e diagnostikimit dhe uljen e vdekshmërisë.
Megjithatë, një vit më vonë, duket sikur pjesa më e madhe e momentumit politik rreth trajtimit të AMR-së është zhdukur tashmë. Dhe ai prag kritik për të vlerësuar se sa afër po i afrohemi rrezikut mungon. Ndërsa ky raport i fundit ofron më shumë prova për të mbështetur idenë se rritja dhe përhapja e infeksioneve rezistente ndaj shumë ilaçeve tani po tejkalon zhvillimin e antibiotikëve, ne ende nuk kemi një metrikë të përcaktuar.
Pa këtë përkufizim, rreziku është që ne do të vazhdojmë të ecim symbyllur drejt një katastrofe globale shëndetësore.
Lajmi i mirë është se ne potencialisht mund të kthehemi nga pragu i greminës. Ndryshe nga pragu i ndryshimit të klimës prej 1.5 gradë Celsius, i njohur gjerësisht si një pikë pa kthim, me AMR-në një përmbysje është e mundur.
Në një moment të jetës sonë, secili prej nesh ka të ngjarë të ketë nevojë për trajtim me antibiotikë. Duke pasur parasysh përdorimin e përhapur mjekësor të këtyre barnave dhe ndikimin e tyre pothuajse të pashembullt në jetën tonë, ne me të vërtetë nuk mund të përballojmë të mos e bëjmë këtë.
*Shkruar nga Dr. Manica Balasegaram, drejtoreshë ekzekutive e Partneritetit Global të Kërkimit dhe Zhvillimit të Antibiotikëve.
Copyright © Gazeta “Si”
Të gjitha të drejtat e këtij materiali janë pronë ekskluzive dhe e patjetërsueshme e Gazetës “Si”, sipas Ligjit Nr.35/2016 “Për të drejtat e autorit dhe të drejtat e tjera të lidhura me to”. Ndalohet kategorikisht kopjimi, publikimi, shpërndarja, tjetërsimi etj, pa autorizimin e Gazetës “Si”, në të kundërt çdo shkelës do mbajë përgjegjësi sipas nenit 179 të Ligjit 35/2016.
.png)